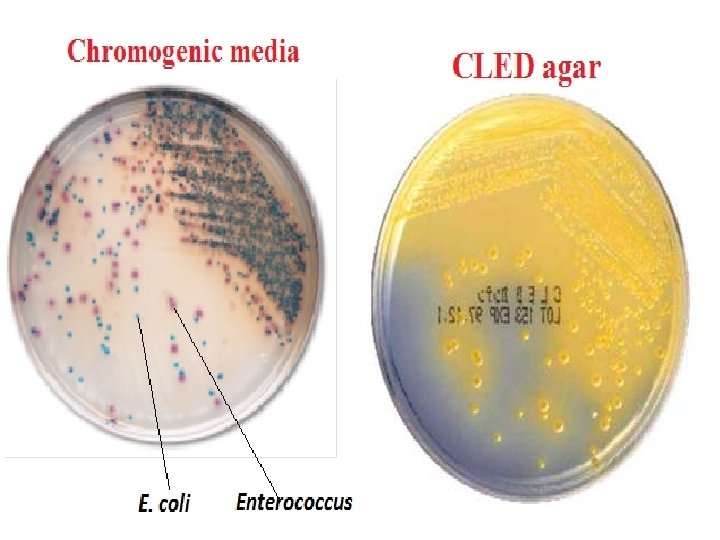

Urinary tract infection UTI Urinary Tract Infection UTI

- Slides: 15
Urinary tract infection (UTI) • Urinary Tract Infection (UTI) is a bacterial infection that affects any part of the urinary tract. A urinary tract infection occurs where bacteria and white blood cells are present in the urine of a patient with symptoms of infection of the urethra, urinary bladder, or the kidney. • The most common type of UTI is acute cystitis often referred to as a bladder infection. An infection of the upper urinary tract or kidney is known as pyelonephritis. • Bacteriuria occurs when bacteria are present in the urine; • pyuria occurs when white blood cells are present in the urine. • The bacteria that cause urinary tract infections are usually of fecal origin (e. g. , Escherichia coli).
Etiology • The most common cause of urinary tract infections (i. e. , urethritis, cystitis, and pyelonephritis) is Escherichia coli. Staphylococcus saprophyticus is the second most common cause of these infections in females between the ages of 13 and 40. • In complicated cases of urinary tract infections such as those resulting from anatomic obstructions or from catheterization, the most common causes are E. coli, Klebsiella pneumoniae, Proteus mirabilis, Enterococcus, and Pseudomonas aeruginosa.
Manifestations • Urethritis: is an infection of the urethra that causes pain and discomfort during voiding (dysuria). • Cystitis: is an infection of the urinary bladder. Signs and symptoms of cystitis include urgency and frequency of urination, voiding small volumes of urine, and supra pubic tenderness just before or immediately after voiding. • Pyelonephritis: is an infection of the urinary tract ascends the ureters to enter the kidneys, the signs and symptoms include fever, flank pain and tenderness, cost vertebral angle tenderness, nausea and vomiting.
Urine Culture • Urine is the specimen most frequently submitted for culture. The most common sites of urinary tract infection (UTI) are the urinary bladder (cystitis) and the urethra. From these sites the infection may ascend into the ureters (ureteritis) and subsequently involve the kidney (pyelonephritis). Females are more prone to infection of the urinary tract than are males. • Factors that increase female susceptibility to UTI: • Short length of the urethra • Urethral contamination by rectal pathogens • Vestibular colonization by pathogenic bacteria • Decreased urethral resistance after menopause
• In both males and females, UTI may be asymptomatic, acute, or chronic. • -Asymptomaic infection can be diagnosed by culture. • -Acute UTI is more frequently seen in females of all ages; these patients are usually treated on an outpatient basis and are rarely admitted to hospital. • -Chronic UTI in both males and females of all ages is usually associated with an underlying disease (e. g. pyelonephritis, prostatic disease, or congenital anomaly of the genitourinary tract) and these patients are most often hospitalized. • Since urine itself is a good culture medium, all specimens should be processed by the laboratory within 2 hours of collection, or be kept refrigerated at 4 C until delivery to the laboratory and processed no longer than 18 hours after collection.
The examination procedure includes the following steps: • 1. Examination of a Gram-stained smear. ( for the presence or absence of bacteria, polymorphonuclear leukocytes, and squamous epithelial cells). One or more bacterial cells per oil-immersion field usually implies that there are 105 or more bacteria per milliliter in the specimen. The presence of one or more leukocytes per oil-immersion field is a further indication of UTI. • 2. A screening test for significant bacteriuria. The absence of leukocytes and bacteria in a Gram-stained smear of a clean catch urine sample prepared as described above is good evidence that the urine is not infected. • A urine specimen that is “negative” on careful examination of the Gram-stained smear does not need to be cultured.
• An alternative simple and effective screening test is the test strip for leukocyte esterase/nitrate reduction. • The strip is dipped into the urine specimen as instructed in the package literature. • Any pink colour is a positive reaction indicating the presence of leukocyte esterase and/or bacteria in excess of 105 per ml. Urine samples that are positive in the screening test should be cultured as soon as possible to prevent possible overgrowth by no significant bacteria. • If the strip does not develop a pink colour it is interpreted as a negative screening test, is so reported, and no culture is indicated. • 3. A definitive culture for urine specimens found to be positive in the screening test. • 4. Susceptibility tests on clinically significant bacterial isolates should only be performed on well-isolated colonies of similar appearance. Susceptibility tests are generally more important on cultures obtained from patients who are hospitalized or have a history of recurring UTI.
Procedure of urine culture • The recommended procedure uses a calibrated plastic or metal loop to transfer 1μl of urine to the culture medium. • 1. Shake the urine gently, then tip it to a slant and with a 1μl inoculating loop touch the surface so that the urine is sucked up into the loop. Never dip the loop into the urine. • 2. Deposit 1μl of the urine on a blood agar plate and streak the plate. • 3. Inoculate the Mac. Conkey agar in the same manner. • 4. Incubate the plates overnight at 35 – 37 Cº.
Culture media for urine culture • The urine samples routinely culture on conventional media (Blood agar and Mac. Conkey agar).
Now urine samples culture on – CLED agar (Cysteine lactose electrolyte deficient agar): CLED agar is now used by most laboratories to isolate urinary pathogens because it gives consistent results and allows the growth of both Gram negative and Gram positive pathogens. It inhibit Proteus swarming and accommodate common pathogens (the indicator in CLED agar is bromothymol blue and therefore lactose fermenting colonies appear yellow). – Chromogenic media
Antibiotic susceptibility test • Sensitivity (susceptibility) testing is used to select effective antimicrobial drugs. The standardized discdiffusion method (Kirby–Bauer) is used. • Disc diffusion techniques are used by most laboratories to test routinely for antimicrobial sensitivity. • A disc of blotting paper is impregnated with a known volume and appropriate concentration of an antimicrobial, and this is placed on a plate of sensitivity testing agar (Mueller–Hinton agar for most bacteria and blood agar for some bacteria) which uniformly inoculated with the test organism. • The antimicrobial diffuses from the disc into the medium and the growth of the test organism is inhibited. Strains sensitive to the antimicrobial are inhibited at a distance from the disc whereas resistant strains have smaller zones of inhibition or grow up to edge of the disc.
• All strains of streptococci should be tested on blood agar for susceptibility. • All Gram-negative rods and staphylococci were tested on Mueller Hinton agar for susceptibility. • Strains of Hemophilus and Neisseria should be tested for susceptibility using Chocolate agar.
Kidney function test • Serum Creatinine • Creatinine is a waste product that comes from meat protein in the diet and also comes from the normal wear and tear on muscles of the body. Creatinine levels in the blood can vary, and each laboratory has its own normal range. In many labs the normal range is 0. 6 to 1. 2 mg/dl. Higher levels may be a sign that the kidneys are not working properly. As kidney disease progresses, the level of creatinine in the blood increases. • Blood Urea Nitrogen (BUN) • Urea nitrogen is produced from the breakdown of food protein. A normal BUN level is between 7 and 20 mg/dl. As kidney function decreases, the BUN level increases.
Th an ky ou